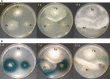

Interactions affect hyphal growth and enzyme profiles in combinations of coniferous wood-decaying fungi of Agaricomycetes
- PMID: 28953947
- PMCID: PMC5617175
- DOI: 10.1371/journal.pone.0185171
Interactions affect hyphal growth and enzyme profiles in combinations of coniferous wood-decaying fungi of Agaricomycetes
Abstract
Fomitopsis pinicola is a species of Polyporales frequently encountered in Nordic temperate and boreal forests. In nature, the fungus causes destructive brown rot in wood, colonizing tree trunks often occupied by other Basidiomycota species. We mimicked these species-species interactions by introducing F. pinicola to five white rot species, all common saprotrophs of Norway spruce. Hyphal interactions and mycelial growth in various combinations were recorded, while activities of lignocellulose-acting CAZymes and oxidoreductases were followed in co-cultures on two different carbon-source media. Of the species, Phlebia radiata and Trichaptum abietinum were the strongest producers of lignin-modifying oxidoreductases (laccase, manganese peroxidase) when evaluated alone, as well as in co-cultures, on the two different growth media (low-nitrogen liquid medium containing ground coniferous wood, and malt extract broth). F. pinicola was an outstanding producer of oxalic acid (up to 61 mM), whereas presence of P. radiata prevented acidification of the growth environment in the liquid malt-extract cultures. When enzyme profiles of the species combinations were clustered, time-dependent changes were observed on wood-supplemented medium during the eight weeks of growth. End-point acidity and production of mycelium, oxalic acid and oxidoreductase activities, in turn clustered the fungal combinations into three distinct functional groups, determined by the presence of F. pinicola and P. radiata, by principal component analysis. Our findings indicate that combinations of wood-decay fungi have dramatic dynamic effects on the production of lignocellulose-active enzymes, which may lead to divergent degradative processes of dead wood and forest litter.
Conflict of interest statement
Figures

References
-
- Rayner A, Boddy L. Fungal Decomposition of Wood—its Biology and Ecology; London, UK: John Wiley & Sons ltd.; 1988.
-
- Lindner DL, Vasaitis R, Kubartová A, Allmér J, Johannesson H, Banik MT, et al. Initial fungal colonizer affects mass loss and fungal community development in Picea abies logs 6 yr after inoculation. Fungal Ecol. 2011;4:449–60.
-
- Rajala T, Peltoniemi M, Pennanen T, Mäkipää R. Fungal community dynamics in relation to substrate quality of decaying Norway spruce (Picea abies [L.] Karst.) logs in boreal forests. FEMS Microbiol Ecol. 2012;81:494–505. doi: 10.1111/j.1574-6941.2012.01376.x - DOI - PubMed
-
- Ottosson E, Nordén J, Dahlberg A, Edman M, Jönsson M, Larsson K-H, et al. Species associations during the succession of wood-inhabiting fungal communities. Fungal Ecol. 2014;11:17–28.
-
- Hiscox J, Savoury M, Johnston SR, Parfitt D, Müller CT, Rogers HJ, et al. Location, location, location: priority effects in wood decay communities may vary between sites. Environ Microbiol. 2016;18:1954–69. doi: 10.1111/1462-2920.13141 - DOI - PubMed
MeSH terms
Substances
LinkOut - more resources
Full Text Sources
Other Literature Sources

